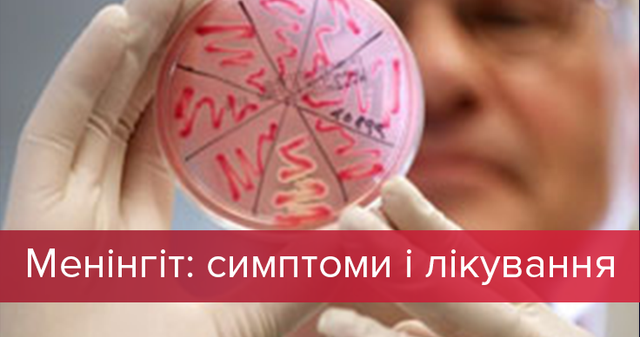

Менінгіт протягом останнього півроку забрав життя трьох дітей в Україні. У травні померло 4-місячне немовля, у липні від менінгіту загинула 4-річна дитина. Останньою жертвою хвороби стала дворічна дівчинка. Що таке менінгіт, як розпізнати симптоми та як лікувати недугу – читайте далі. Що таке менінгіт Це запалення м'якої мозкової оболонки, що покриває головний і спинний мозок людини. Якщо вчасно виявити недугу, то її лікування пройде відносно швидко і без наслідків. Однак, якщо ж лікування "запустити", то це може мати навіть летальний наслідок. Різновиди менінгіту Менінгококовий менінгіт У перші дні зараження у хворих з'являється геморагічний висип, озноб та лихоманка. У той же час в крові відбуваються гострі запальні зміни. Якщо не приступити до лікування вчасно, то смертність при цьому менінгіті становить 50%. Пневмококовий менінгіт У більшості випадків такий менінгіт провокує перенесена пневмонія або синусит (запалення слизової оболонки біля носових повітряних пазух). У цьому випадку менінгітові симптоми проявляються дещо пізніше. Навіть якщо хворобу виявити вчасно, вона дуже швидко прогресує. Можуть з'явитися судоми та розлади свідомості. Навіть якщо лікування почати вчасно, смертність становить 15 – 25%. Менінгіт, який викликала гемофільна паличка На цей менінгіт найчастіше хворіють діти до року. Майже одразу у немовлят з'являється лихоманка, а також можливе часте зригування або блювання. Вірусний менінгіт Найчастіше перші симптоми нагадують грип і тільки через кілька днів з'являються деякі ознаки менінгіту. Хворі погано себе почувають, мають сильний головний біль, однак інші серйозні симптоми менінгіту, як втрата свідомості, не проявляються. Туберкульозний менінгіт Хвороба починається з гарячки, через кілька днів починається блювота та сильний головний біль. Через 2 тижні після зараження хвороба уражує мозок. Смертність при цій хворобі становить від 15 до 25%. Менінгіт у дітей Діти до 5 років – це найбільша група ризику заразитись менінгітом. Саме у цьому віці ця хвороба має особливо серйозну небезпеку, серйозними є й ускладення від меннігіту. Один із симптомів – висока температура Найважча форма дитячого менінгіту розвивається при інфікуванні стрептококовою агалактією. Заразитись цим мікроорганізмом немовля може при народженні від матері. У цьому випадку хвороба протікає блискавично та викликає серйозні наслідки, навіть смерть дитини. Серед дітей у віці від 1 до 5 років найбільш поширеним є вірусний менінгіт. Зазвичай він має не такі серйозні наслідки. Бактеріальний менінгіт, викликаний менінгококом, пневмококом і гемофільною паличкою, протікає у дітей значно важче, тож для захисту медики рекомендують робити вакцинацію. Симптоми менінгіту у дітей Загальні симптоми менінгіту характеризуються підвищенням температури, ознобом, тахікардією, поганим апетитом. Тож часто батьки можуть сплутати цю хворобу із застудою чи грипом. При цьому існують деякі симптоми, що мають стати тривожним дзвінком для батьків, щоб негайно звернутись до лікаря. Сильний головний біль Біль поширюється по всій голові, при цьому напади болю дуже сильні. Від цього діти починають плакати чи навіть кричати. Висипання Одразу з перших днів захворювання на тілі у дитини виникають дрібні темно-вишневі цяточки при легкій формі менінгіту, а при важкій можуть з'явитися навіть великі плями чи синці. Сплутана свідомість та епілептичні напади Постійна блювота Підвищення чутливості Очі починають болісно реагувати на світло, дитина важко реагує на гучні звуки чи навіть дотики. Симптом Керніга Щоб визначити цей симптом, батькам треба покласти дитину на спину і зігнути ногу в тазостегновому і колінному суглобі. Далі треба спробувати розігнути тільки в коліні. При менінгіті нога в дитини повністю не розігнеться і з'явиться різкий біль у попереку. Як визначити симптом Керніга Лікування менінгіту у дітей Навіть якщо є тільки підозра менінгіту, дитину одразу госпіталізують в інфекційний стаціонар. Під час гострого періоду дітям призначається постільний режим, максимальний спокій, дієта. Крім того, відповідно до форми хвороби дітям призначають антибактеріальні препарати. Тривалість антибіотикотерапії при менінгіті становить не менше 10-14 днів. При вірусному менінгіті проводять противірусну терапію. Якщо відбувається важкий перебіг захворювання, то дитині необхідна респіраторна підтримка. Після того, як дитина одужала, вона ще деякий час перебуває на контролі педіатра, інфекціоніста та невролога. Менінгіт у дорослих: симптоми та лікування Багато хто вважає менінгіт дитячою хворобою. Якась доля правди у цьому є – за статистикою від запалення мозку в 90% випадків страждають саме діти. При цьому дорослі у 9 з 10 випадків є лише носіями цього захворювання, симптоми з'являються рідко. Як правило, в організмі дорослої людини бактерії, що провокують менінгіт, викликають тонзиліт або ангіну. Однак, в окремих випадках інфекція може дійти і до мозку, провокуючи запалення. У дорослого менінгіт найчастіше може виникнути як ускладнення гаймориту, туберкульозу тощо. Симптоми у дорослого такі ж, як і в дітей – сильний головний біль, висипання, блювота та підвищена чутливість. Симптом менінгіту – висипка Лікування теж відбувається тільки у лікарняних умовах. Дорослому виписують антибактеріальні препарати. Як правило, всі препарати вводять внутрішньовенно або в спинномозковий канал – якщо хвороба загрожує життю пацієнта. Тривалість терапії становить тиждень або й більше. Менінгіт майже завжди супроводжується сильною інтоксикацією організму, тому під час лікування виводять токсини. Для цього хворому вводять фізіологічний розчин через крапельницю чи уколи.
Менінгіт протягом останнього півроку забрав життя трьох дітей в Україні. У травні померло 4-місячне немовля, у липні від менінгіту загинула 4-річна дитина. Останньою жертвою хвороби стала дворічна дівчинка. Що таке менінгіт, як розпізнати симптоми та як лікувати недугу – читайте далі. Що таке менінгіт Це запалення м'якої мозкової оболонки, що покриває головний і спинний мозок людини. Якщо вчасно виявити недугу, то її лікування пройде відносно швидко і без наслідків. Однак, якщо ж лікування "запустити", то це може мати навіть летальний наслідок. Різновиди менінгіту Менінгококовий менінгіт У перші дні зараження у хворих з'являється геморагічний висип, озноб та лихоманка. У той же час в крові відбуваються гострі запальні зміни. Якщо не приступити до лікування вчасно, то смертність при цьому менінгіті становить 50%. Пневмококовий менінгіт У більшості випадків такий менінгіт провокує перенесена пневмонія або синусит (запалення слизової оболонки біля носових повітряних пазух). У цьому випадку менінгітові симптоми проявляються дещо пізніше. Навіть якщо хворобу виявити вчасно, вона дуже швидко прогресує. Можуть з'явитися судоми та розлади свідомості. Навіть якщо лікування почати вчасно, смертність становить 15 – 25%. Менінгіт, який викликала гемофільна паличка На цей менінгіт найчастіше хворіють діти до року. Майже одразу у немовлят з'являється лихоманка, а також можливе часте зригування або блювання. Вірусний менінгіт Найчастіше перші симптоми нагадують грип і тільки через кілька днів з'являються деякі ознаки менінгіту. Хворі погано себе почувають, мають сильний головний біль, однак інші серйозні симптоми менінгіту, як втрата свідомості, не проявляються. Туберкульозний менінгіт Хвороба починається з гарячки, через кілька днів починається блювота та сильний головний біль. Через 2 тижні після зараження хвороба уражує мозок. Смертність при цій хворобі становить від 15 до 25%. Менінгіт у дітей Діти до 5 років – це найбільша група ризику заразитись менінгітом. Саме у цьому віці ця хвороба має особливо серйозну небезпеку, серйозними є й ускладення від меннігіту. Один із симптомів – висока температура Найважча форма дитячого менінгіту розвивається при інфікуванні стрептококовою агалактією. Заразитись цим мікроорганізмом немовля може при народженні від матері. У цьому випадку хвороба протікає блискавично та викликає серйозні наслідки, навіть смерть дитини. Серед дітей у віці від 1 до 5 років найбільш поширеним є вірусний менінгіт. Зазвичай він має не такі серйозні наслідки. Бактеріальний менінгіт, викликаний менінгококом, пневмококом і гемофільною паличкою, протікає у дітей значно важче, тож для захисту медики рекомендують робити вакцинацію. Симптоми менінгіту у дітей Загальні симптоми менінгіту характеризуються підвищенням температури, ознобом, тахікардією, поганим апетитом. Тож часто батьки можуть сплутати цю хворобу із застудою чи грипом. При цьому існують деякі симптоми, що мають стати тривожним дзвінком для батьків, щоб негайно звернутись до лікаря. Сильний головний біль Біль поширюється по всій голові, при цьому напади болю дуже сильні. Від цього діти починають плакати чи навіть кричати. Висипання Одразу з перших днів захворювання на тілі у дитини виникають дрібні темно-вишневі цяточки при легкій формі менінгіту, а при важкій можуть з'явитися навіть великі плями чи синці. Сплутана свідомість та епілептичні напади Постійна блювота Підвищення чутливості Очі починають болісно реагувати на світло, дитина важко реагує на гучні звуки чи навіть дотики. Симптом Керніга Щоб визначити цей симптом, батькам треба покласти дитину на спину і зігнути ногу в тазостегновому і колінному суглобі. Далі треба спробувати розігнути тільки в коліні. При менінгіті нога в дитини повністю не розігнеться і з'явиться різкий біль у попереку. Як визначити симптом Керніга Лікування менінгіту у дітей Навіть якщо є тільки підозра менінгіту, дитину одразу госпіталізують в інфекційний стаціонар. Під час гострого періоду дітям призначається постільний режим, максимальний спокій, дієта. Крім того, відповідно до форми хвороби дітям призначають антибактеріальні препарати. Тривалість антибіотикотерапії при менінгіті становить не менше 10-14 днів. При вірусному менінгіті проводять противірусну терапію. Якщо відбувається важкий перебіг захворювання, то дитині необхідна респіраторна підтримка. Після того, як дитина одужала, вона ще деякий час перебуває на контролі педіатра, інфекціоніста та невролога. Менінгіт у дорослих: симптоми та лікування Багато хто вважає менінгіт дитячою хворобою. Якась доля правди у цьому є – за статистикою від запалення мозку в 90% випадків страждають саме діти. При цьому дорослі у 9 з 10 випадків є лише носіями цього захворювання, симптоми з'являються рідко. Як правило, в організмі дорослої людини бактерії, що провокують менінгіт, викликають тонзиліт або ангіну. Однак, в окремих випадках інфекція може дійти і до мозку, провокуючи запалення. У дорослого менінгіт найчастіше може виникнути як ускладнення гаймориту, туберкульозу тощо. Симптоми у дорослого такі ж, як і в дітей – сильний головний біль, висипання, блювота та підвищена чутливість. Симптом менінгіту – висипка Лікування теж відбувається тільки у лікарняних умовах. Дорослому виписують антибактеріальні препарати. Як правило, всі препарати вводять внутрішньовенно або в спинномозковий канал – якщо хвороба загрожує життю пацієнта. Тривалість терапії становить тиждень або й більше. Менінгіт майже завжди супроводжується сильною інтоксикацією організму, тому під час лікування виводять токсини. Для цього хворому вводять фізіологічний розчин через крапельницю чи уколи.2 3
Комментариев нет:
Отправить комментарий